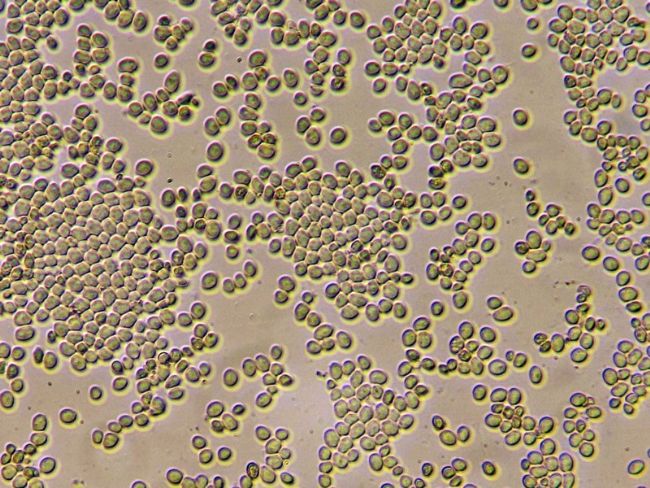

顯微鏡能怎樣看細菌?
顯微鏡能看細菌,是大部分人對顯微鏡的直觀認知;把手放在顯微鏡下看細菌,是大部分小朋友的直覺操作……當然,這樣可看不到細菌,那么顯微鏡應該怎么看細菌呢?今天我們就來盤盤細菌鏡檢的方式。

·常規細菌鏡檢方式:生物顯微鏡 + 革蘭氏染色等明場染色

生物顯微鏡ML51(左)和ML51-N(右)
細菌和真菌尺寸都非常小,直接觀察非常難看清,因此一般細菌觀察都需要經過染色,其中最經典的方法是革蘭氏染色。

革蘭氏染色是使用廣泛的一種細菌鑒別方法,革蘭氏陽性菌染色后呈紫色,陰性菌呈紅色,染色后不僅可以看清細菌型態、排列和結構特征,還對抗生素選擇有指導意義。我們來給大家看看一些常見的細菌經過革蘭氏染色后的樣子。

這是蠟樣芽孢桿菌,呈紫色桿狀,革蘭氏陽性菌,可引起食物中毒、嘔吐。

這是肉毒桿菌,總體呈紫色,革蘭氏陽性菌,其次極端有陰性反應的芽孢,呈紅色,總體形狀看起來像個湯匙,會產生劇毒的肉毒毒素。

為了呈現細菌鞭毛,還有專門的鞭毛染色法,比如Leifson氏鞭毛染色法和Bailey氏鞭毛染色法,可以將鞭毛染成紅色,以便生物顯微鏡觀察。

抗酸染色下的桿菌(紅色)
革蘭氏染色主要問題是步驟比較繁瑣,如果不需要分辨革蘭氏陽性陰性,那么也可以簡單點用吉姆薩染色或者抗酸染色等方法。另外由于細菌尺寸很小,用低倍鏡檢容易漏,檢出率不理想,而如果用100X油浸物鏡高倍鏡檢,小批量還能處理,大批量的話效率堪憂。

熒光顯微鏡下的細菌
為了提升細菌和真菌的檢出率,很多醫院目前都已經改用了明美的熒光顯微鏡做熒光鏡檢。

熒光觀察下的念珠菌(紅色)
熒光染色劑可以將細菌、真菌等目標特異性染色,經過熒光顯微鏡激發觀察,目標將會呈現明亮的熒光反應,而背景和其他無關目標將呈現為暗色到純黑,即便用低倍物鏡也能快速發現這些熒光反應,從而大大提升診斷的速度和準確性。
不同的熒光染料可以染色不同的細菌,可以據此快速判斷是否存在特定種類細菌,我們來給大家分享下一些常見的細菌在熒光顯微鏡下的樣子。

大腸桿菌,上廁所不洗手可能會感染,導致腹瀉。

沙門氏菌,生吃雞蛋容易感染,導致食物中毒。

結核桿菌,會導致結核病,屬于呼吸道七聯檢之一,其他還有六種病原體也是用熒光觀察進行判定的。

新生隱球菌,常見于鴿糞的致病真菌,對免疫力低的人能造成較大傷害。

白念珠菌,也是常見真菌,正常人也會有少量,免疫力低可能會失控增殖進而致病。
·普通人看細菌的方法:一臺靠譜顯微鏡 + 四種簡單方法

醫院用ML51-N看血涂片
上面都是科研和醫療層面常用的細菌觀察方式,不僅需要比較高預算的儀器設備和配套耗材,還需要比較強的專業技能,那么普通人想看細菌能怎么做呢?

首先是選擇一臺靠譜的顯微鏡。這里要糾正一個某寶、某多多等電商平臺的概念誤導,不存在什么“上萬倍放大的光學顯微鏡”。由于光學限制,一般的顯微鏡放大倍率上限在1000倍左右,也就是100X物鏡搭配10X目鏡,就到頭了,所謂萬倍放大只會讓成像偏暗且模糊,沒有意義。

生物顯微鏡ML11
常規的生物顯微鏡,如很多學校在用的ML11,標配4X/10X/40X/100X四種物鏡,可以用40X或者100X看細菌。正常渠道四個倍率全齊的新機肯定要千元以上,低于千元的畫質和做工堪憂,不建議買,關注明美看圖就好了。使用100X油浸物鏡可以看到更豐富的細菌細節,但這種高倍油浸物鏡使用比較難,需要先學習、準備好耗材再操作。

吉薩姆染色下的細菌
有靠譜儀器后,下一步就是方法了。首先是經典的明場染色,革蘭氏染色耗材比較多,步驟比較繁雜,不建議普通人從這個方法上手,建議選擇吉薩姆染色,耗材和步驟相對簡單,而且染色液也相對革蘭氏染色液更便宜。
如果不想倒騰染色,也有三種不染色的方法。

相襯觀察下的支原體(小黑點)
第一種方法是相襯觀察。相襯觀察是適合看未染色的細胞、細菌等樣品的科學方法,它能將樣品厚度差異轉化為圖像對比度,從而勾勒出樣品的型態。相襯觀察需要專門的相襯物鏡和相襯聚光鏡,倒置顯微鏡通常會配備這些,正置顯微鏡也能通過升級相襯物鏡和相襯聚光鏡實現,但相襯套裝通常比較貴。

暗場下的血紅細胞
第二種方法是暗場觀察。暗場觀察利用的是丁達爾效應,就是陽光斜照讓灰塵都清晰可見的那種現象,它可以形成黑背景、亮樣品的高對比度圖像。暗場觀察可以通過簡易暗場聚光鏡實現,只需在聚光鏡下安裝暗場環,然后把聚光鏡調到最高位置觀察即可,ML31等生物顯微鏡有標配的暗場環可以選購。
斜照明下的酵母菌
最后一種方法是斜照明觀察。這種方法可以讓透明樣品形成強立體感,但會形成明顯的色差(紫邊、彩色邊),同時畫面亮度會不均勻。生物顯微鏡可以0成本體驗,方法很簡單,直接把手伸到阿貝聚光鏡底部,將大部分光照遮住,留下邊緣一條縫,一邊觀察一邊調整手遮的位置和方向,直到你感覺效果最好。明美體視顯微鏡MZX100可調角度透射式底座就是利用斜照明技術,可以用于觀察透明的卵母細胞等樣品。
總結:用顯微鏡看細菌還真不是簡單操作,需要成像質量好的生物顯微鏡或熒光顯微鏡,方法包括革蘭氏染色等明場染色、FITC-D-Lys等熒光染色、相襯觀察、暗場觀察和斜照明觀察。對于大型醫院等機構,MF31-M熒光生物顯微鏡還是很好的選擇,快捷高效;其他機構可以考慮ML31/ML11生物顯微鏡搭配革蘭氏染色等明場染色;簡易暗場和斜照明技術要求和成本要求相對低,但效果也相對難調好,只建議普通用戶嘗試。
免責聲明
本站無法鑒別所上傳圖片、字體或文字內容的版權,如無意中侵犯了哪個權利人的知識產權,請來信或來電告之,本站將立即予以刪除,謝謝。
來源:https://www.mshot.com/article/1619.html